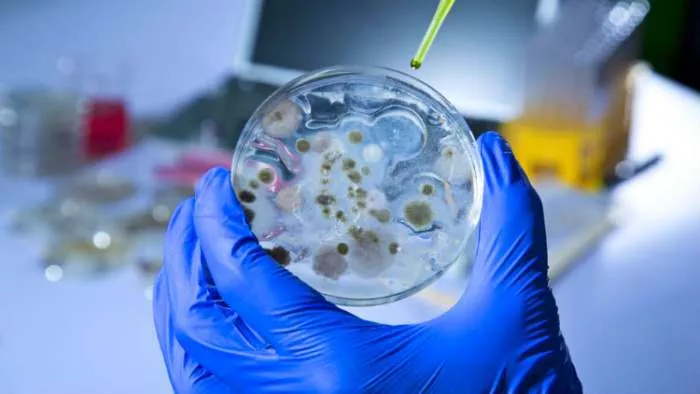
otpornost ešerihije

REZISTENTNOST BAKTERIJE NA LEK
Bakterije se sve više menjaju i mutiraju, pa se tako povećava i njihova otpornost na antibiotike. Otpornost ešerihije je, kažu najnovija medicinska istraživanja, sve je jača ukoliko se tretira medikamentima. Jedan od najvećih problema današnjice, kako tvrdi SZO, jeste upravo sve veća rezistencija bakterija na lekove.
Nova medicinska studija ustvrdila je da antibiotici zaista mogu izazvati brži rast populacije bakterija, čak brže nego kada su prepuštene same sebi. U skladu sa ovim otkrićem, pokazano je da bakterija ešerihija koli (Escherichia coli), koja je najpoznatija kao izazivač trovanja hranom, razvija veći otpor prema antibioticima sa svakom novom dozom.
Ovakav nalaz verovatno nije ono što su naučnici očekivali da će otkriti, jer on znači da je ljudska populacija pod naletom sve više vrsta bakterija koje su otporne na antibiotike.
Bakterije prolaze kroz neočekivane evolucione promene
Ovu naučnu studiju sproveli su istraživači sa Univerziteta u engleskom gradu Eksiter, a oni su ešerihiju izložili antibioticima i to u osam tura tokom samo četiri dana, kako bi mogli da prouče sve promene koje su se desile na DNK. Rezultati su bili šokantni – ne samo da su bakterije postale sve otpornije na antibiotike, već su mutirane bakterije počele da se razmnožavaju mnogo brže.
Sa ovim novim promenama, ešerihija je bila u stanju da utrostruči svoj broj. Ovaj fenomen je bio viđen samo kod bakterija koje su bile izložene antibioticima, a čak i kada je dejstvo antibiotika prestalo, mutacije su ostale prisutne i aktivne.
Nakon što je došlo do evolucije ove bakterije, istraživači su je zamrznuli na određenoj temperaturi, odakle su uspeli da utvrde koje su se promene na DNK desile i omogućili bakterijama da evoluiraju u “superbakterije”.
“Naše istraživanje pokazuje koliko bakterija ešerihija može da razvije otpornost na antibiotike. Bakterije imaju izuzetnu sposobnost da preurede svoj DNK i takve nagle promene mogu biti veoma opasne za ljudske ćelije”, objašnjava vodeći autor ove studije, profesor Robert Berdmor.
Otpornost na antibiotike je sve veći problem
Doktor Mark Hevlet, takođe sa Univerziteta u Eksiteru, kaže da iako se često veruje da visoka doza antibiotika može da spreči razvoj otpora na antibiotike, istraživanje tima je pokazalo da to jednostavno nije istina. Hevlet kaže da njihov rad pokazuje da se otpor zaista može još razvijati i kada su antibiotici aktivirani. On je dodao da se bakterije menjaju na način koji nikako ne ide u korist lečenju određenih vrsta infekcija.
Otpornost na antibiotike se smatra jednom od najvećih pretnji globalnog zdravlja. Svetska zdravstvena organizacija (SZO) kaže da je preterana upotreba i zloupotreba antibiotika kod ljudi i životinja jedan od glavnih uzroka porasta otpornosti na njih.
Postoje mnoge prirodne alternative antibiotika koje se mogu koristiti za lečenje određenih zdravstvenih stanja. Problem otpornosti bakterija na antibiotike neće nestati sve dok ne prestane nenamerno stvaranje ovakvih bakterija.